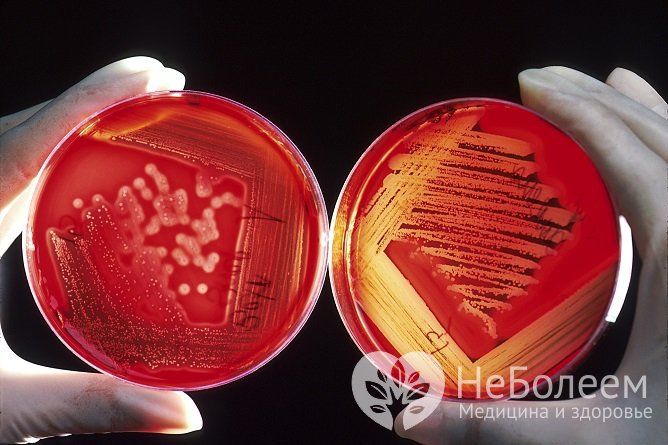

Воспользуйтесь поиском по сайту:
Отличается ли пневмония от воспаления легких
Содержание статьи:
Чем отличается пневмония от воспаления легких? Этот вопрос часто интересует людей, у которых появляются первые симптомы заболевания. Среди врачей разницы между этими двумя понятиями нет, поскольку они означают одну и ту же патологию. При этом достаточно распространено ошибочное мнение, что это две отдельные болезни.
 Поставить диагноз и определить, как называется болезнь, может только квалифицированный врач
Поставить диагноз и определить, как называется болезнь, может только квалифицированный врачПневмония (pneumonia; греч. pneumon – легкое) является собирательным термином, объединяющим целую группу заболеваний, проявляющихся посредством воспалительного процесса в тканях легких (т. е. воспаления легких).
При появлении первых признаков болезни рекомендуется обратиться за консультацией к врачу-пульмонологу для постановки точного диагноза. Проявления заболевания во многом схожи с таковыми при иных инфекциях.
Терапия патологии в первую очередь должна быть направлена на уничтожение патогена, ставшего причиной ее развития. При легком течении инфекции, по согласованию с врачом, лечение может проводиться в домашних условиях, тогда как в случаях тяжелой формы требуется экстренная госпитализация в отделение интенсивной терапии.
Как развивается болезнь
Патологию вызывают патогенные микроорганизмы – вирусы, бактерии, грибы, простейшие, спирохеты.
 К развитию патологии приводят различные инфекционные агенты, включая вирусы и бактерии
К развитию патологии приводят различные инфекционные агенты, включая вирусы и бактерииВ легочную ткань они чаще всего попадают бронхогенным путем, чему способствует:
- аспирация – вдыхание микробов из окружающей среды;
- переселение патогенной флоры из верхних отделов дыхательной системы в нижние;
- искусственная вентиляция легких;
- проведение медицинских манипуляций – интубация трахеи, бронхоскопия;
- ингаляция из обсемененных ингаляторов.
Менее распространенными путями заражения являются гематогенный и лимфогенный. В первом случае инфекция распространяется с током крови на фоне септических процессов, внутриутробного заражения, а также при наркомании, когда наркотические вещества вводятся внутривенно нестерильными шприцами.
Возникновение патологии наиболее часто наблюдается при снижении иммунитета, которое может быть связано с частыми переохлаждениями, приемом иммуносупрессивных препаратов, а также с перенесенной вирусной болезнью.
Другие факторы риска:
- врожденные нарушения бронхолегочной системы;
- табакокурение, чрезмерное употребление алкоголя;
- пожилой возраст;
- сопутствующий сахарный диабет, сердечно-сосудистые заболевания, паркинсонизм;
- хирургические вмешательства, перенесенные недавно;
- травмы легких.
Виды воспаления легких
Выделяют следующие разновидности пневмоний:
|
Критерий |
Виды |
Характеристика |
|
По эпидемиологическим данным |
Возникает в домашних условиях или на протяжении первых 2 суток пребывания в больнице |
|
|
Внутрибольничные |
Появляется по прошествии 2 суток пребывания в стационаре |
|
|
По распространенности воспалительного процесса |
Патогены образуют очаг на небольшой части легкого |
|
|
Инфекция распространяется на один или несколько сегментов органа дыхания |
||
|
Долевая |
Заражена доля легкого |
|
|
Сливная |
Мелкие очаги воспаления сливаются в более крупные |
|
|
Односторонняя |
Поражено одно легкое |
|
|
Заражены оба легких |
||
|
Тотальная |
Инфекция распространяется на все легкое |
|
|
По механизму развития |
Первичная |
Является самостоятельным заболеванием |
|
Вторичная |
Развивается в качестве осложнения основной патологии |
|
|
Появляется при попадании инородного тела в бронхи |
||
|
Посттравматическая |
Возникает вследствие повреждений грудной клетки, на фоне которых задерживается бронхиальный секрет и нарушается вентиляция легких |
|
|
Радиационная |
Развивается после рентгенорадиевой терапии при онкологии |
|
|
Инфаркт-пневмония |
Пусковым механизмом выступает тромбоэмболия мелких сосудистых ветвей легочной артерии |
|
|
По природе происхождения |
Развивается под воздействием стрептококков, стафилококков, пневмококков, клебсиелл, легионелл |
|
|
Патогенами являются вирусы парагриппа, гриппа, Эпштейна – Барр, аденовирусы, цитомегаловирус |
||
|
Грибковая |
Возбудителями выступают пневмоцисты, плесневые, эндемичные диморфные и дрожжеподобные грибы |
|
|
Смешанная |
Развивается под сочетанным влиянием двух или большего числа патогенных микроорганизмов |
|
|
По характеру течения |
Острая |
Делится на остротекущую (до 21 суток) и затяжную (до 2 месяцев) |
|
Подострая |
Длится на протяжении 21–42 суток |
|
|
Хроническая |
Проявления слабоинтенсивные, протекает длительно – от нескольких месяцев до многих лет и даже десятилетий |
|
|
По тяжести течения |
Легкая |
Слабовыраженная интоксикация, температура тела субфебрильная (до 38 °С), очаг воспаления небольшой |
|
Среднетяжелая |
Интоксикация умеренно-выраженная, лихорадка достигает значений в 39 °С, инфильтрация легких выраженная |
|
|
Тяжелая |
Выраженная интоксикация с повышением температуры тела до 41 °С, обширная инфильтрация легких, развитие тяжелых осложнений |
Чем отличается пневмония от воспаления легких
Воспаление легких неинфекционной этиологии может возникать в следующих случаях:
- состояния, развившиеся под влиянием вредных химических и физических факторов;
- врожденные и приобретенные дефекты ферментативных систем;
- аллергические болезни;
- диффузные болезни соединительной ткани.
Поражение легких, не связанное с инфекцией, называется:
- пневмонит: если воспаление затрагивает главным образом респираторные отделы легких;
- альвеолит: при преимущественном диффузном воспалительном поражении терминальных отделов дыхательных путей (альвеол).
Опасность пневмонитов и альвеолитов состоит в том, что на их фоне нередко развивается бактериальная, вирусно-бактериальная либо грибковая пневмония.
Таким образом, единственным отличием пневмонии и воспалительного процесса в легких можно назвать то, что пневмония – инфекционное заболевание, а воспаление легочной ткани может быть как инфекционной, так и неинфекционной этиологии.
Как проявляется воспаление легких
К наиболее характерным признакам патологии относятся:
- сухой кашель, постепенно перетекающий во влажный с отхождением мокроты;
- одышка;
- увеличение температуры тела от субфебрильных показателей до 41 °С, в зависимости от вида заболевания и возбудителя;
- потливость;
- слабость;
- озноб;
- боль в грудной клетке, усиливающаяся при кашле или глубоком дыхании;
- ощущение нехватки воздуха в спокойном состоянии.
 Для заболевания характерно повышение температуры тела, слабость, озноб
Для заболевания характерно повышение температуры тела, слабость, ознобОсобенности течения болезни и то, сколько по времени будет болеть человек, напрямую зависит от его состояния, степени тяжести воспалительного процесса, свойств патогенных микроорганизмов и присоединения осложнений.
Диагностика патологии
Важными составляющими для подбора эффективной терапии является своевременное выявлении инфекции, дифференциальная диагностика с иными патологиями органов дыхания, включая бронхит и ОРВИ, определение возбудителя и тяжести течения болезни.
Прежде всего пульмонолог проводит внешний осмотр и собирает данные анамнеза, включая жалобы больного. Интоксикация, быстрое развитие лихорадки и сильный кашель являются теми проявлениями, при наличии которых врач в первую очередь заподозрит воспаление легких.
 Для подтверждения диагноза и выявления возбудителя необходимо пройти соответствующие исследования
Для подтверждения диагноза и выявления возбудителя необходимо пройти соответствующие исследованияНеобходимый диагностический минимум:
- рентгенографическое исследование: проводится в обязательном порядке. Если на полученных снимках обнаруживаются затемнения в нижней доле легких или усиление легочного рисунка – диагноз пневмония подтверждается. Для контроля разрешения воспаления рентгенограмму повторяют спустя 3–4 недели после первого исследования;
- анализы: перечень анализов, осуществляемых в ходе диагностики, включает общий и клинический анализ крови, а также исследования мочи. О наличии патологии свидетельствует увеличение скорости оседания эритроцитов, сдвиг лейкоцитарной формулы, наличие лейкоцитоза, обнаружение протеинурии или, значительно реже, микрогематурии;
- исследование мокроты: после подтверждения диагноза пульмонолог дает пациенту направление на исследование мокроты с целью выявления возбудителя. Если по его результатам определяется бактериальная природа болезни, проводят антибиотикограмму для выявления резистентности или чувствительности патогенна к разным группам антибиотиков.
Читайте также:Современные антибиотики: эффективность и побочное действие
Терапия
В подавляющем большинстве случаев лечение заболевания проводят в условиях стационара, во избежание развития опасных осложнений, включая плеврит, острую дыхательную недостаточность, инфекционно-токсический шок и в крайних случаях – летального исхода. Рекомендовать терапию на дому врач может при легком течении инфекции и только при условии четкого соблюдения пациентом прописанной схемы.
Лечение в первую очередь должно быть направлено на уничтожение возбудителя болезни
Лечение в первую очередь должно быть направлено на уничтожение возбудителя болезниВ ходе проводимого лечения должны реализовываться следующие цели:
- эрадикация микроорганизма, вызвавшего воспаление;
- купирование проявления патологии;
- нормализация функциональных нарушений органа дыхания и лабораторных показателей;
- разрешение инфильтративных изменений в ткани легкого;
- профилактика потенциальных осложнений заболевания.
Препаратами первой линии при болезни выступают те, действие которых направленно на устранение клеток-возбудителей – антибиотики, реже – противовирусные или противогрибковые средства. В дополнении к таким средствам для снижения выраженности симптомов применяются:
- противовоспалительные, противокашлевые, жаропонижающие лекарства;
- бронхолитики;
- растворы для ингаляций;
- методы физиотерапии – электрофорез рассасывающих средств, магнитотерапия, прогревание легких;
- дыхательная гимнастика;
- массаж грудной клетки;
- рецепты народной медицины.
Наиболее эффективными при пневмонии считаются такие лекарственные средства, как:
- антибактериальные: Аугментин, Амоксиклав, Азимед, Сумамед, Роксибид, Клацид;
- антибиотики резерва: Моксимак, Спарфло, Супракс, Левофлокс, Цедекс;
- противовирусные: Цитотект, Хумаглобин, Фоскарнет, Ганцикловир;
- противогрибковые: Кетоконазол, Итраконазол, Флуконазол, Амфотерицин;
- противовоспалительные: Ибупрофен, Нимесулид;
- жаропонижающие: Парацетамол, Фервекс, Терафлю;
- противокашлевые: Ацетилцистеин, Эрдостеин, Бронхикум, Бромгексин, Аскорил;
- бронхолитики: Теофиллин, Беродуал, Сальбутамол, Фенотерол, Эуфиллин.
В период лечения пациентам следует соблюдать щадящий режим – ограничить физические нагрузки, принимать неострую мягкую теплую пищу, в большом количестве пить теплую жидкость.
Также важно ограничить контакты с окружающими лицами, во избежание передачи инфекции друг другу.
Нетрадиционное лечение заболевания
По рекомендации врача, для улучшения состояния больного и снижения проявлений болезни, могут использоваться рецепты народной медицины, а именно:
- рецепт №1: ½ л дегтя медицинского вливают в стеклянную банку объемом 3 л, заливают кипятком до полного заполнения тары. Банку плотно закрывают крышкой и держат в теплом месте на протяжении 9 суток. Готовое средство принимают перорально перед сном, не запивая водой, взрослые – по 1 ст. ложке, дети – по 1 ч. ложке, утром жидкость используют для полоскания горла;
- рецепт №2: 1 ч. ложку корней и листьев мать-и-мачехи смешивают с таким же количеством душицы, заливают 1 л кипятка и настаивают на протяжении 1 ч. Готовый травяной настой пьют по ½ стакана 2 раза в сутки перед приемом пищи;
- рецепт №3: равные части (по 1 ст. ложке) плодов аниса, сосновых почек, корней алтея, листьев солодки и шалфея смешивают, заливают 1 л горячей кипяченой воды и отваривают на медленном огне в течение 15 мин. Далее отвар процеживают, остужают и принимают по ¼ стакана каждые 3 ч;
- рецепт №4: несколько листьев алоэ заливают 250 мл красного вина и добавляют 1 ч. ложку жидкого меда. Бальзам настаивают 14 суток, а затем пьют по 1 ст. ложке перед приемом пищи 3 раза в день.
Принимать домашние препараты следует только по назначению врача, поскольку учесть наличие у больного противопоказаний к таким средствам и возможные побочные эффекты от их приема может только специалист. Важно при приготовлении народных лекарств соблюдать рекомендуемые пропорции и не превышать назначенных дозировок.
Профилактика воспаления легких
Меры профилактики должны быть направлены на предотвращение повторного развития заболевания.
 Одна из эффективных профилактических мер развития заболевания – отказ от курения
Одна из эффективных профилактических мер развития заболевания – отказ от куренияПациентам и здоровым лицам, находящимся в группе риска, рекомендуется:
- вакцинация пневмококковой или гриппозной вакциной;
- отказ от курения;
- закаливание организма;
- рациональное питание;
- лечебная физкультура, регулярные физические нагрузки;
- ежегодное посещение лечебных курортов для прохождения климатолечебных процедур.
Пневмония и воспаление легких – это одно и то же заболевание. Особое значение для полного уничтожения очага инфекции, купирования проявлений и предотвращения потенциальных осложнений имеет раннее начало адекватной терапии. В связи с этим при появлении первых симптомов болезни рекомендуется обратиться за консультацией к пульмонологу.
Видео
Предлагаем к просмотру видеоролик по теме статьи.
Об авторе

Нашли ошибку в тексте? Выделите ее и нажмите Ctrl + Enter.
В нашем кишечнике рождаются, живут и умирают миллионы бактерий. Их можно увидеть только при сильном увеличении, но, если бы они собрались вместе, то поместились бы в обычной кофейной чашке.
























